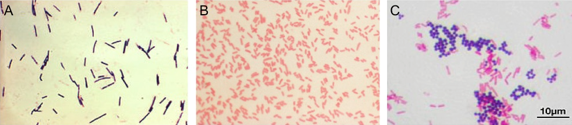

True or False: Most cells are relatively transparent
True
Stains can be used to examine ___1___, ___2___or even ___3___.
- tissues (muscle or connective)
- specific types of cells (blood, bacterial, etc.)
- organelles within an individual cell (nucleus, ER, etc.)
Gram staining was first developed by ___1___ in the year ___2___ and is still used to this day.
- Hans Christian Gram
- 1884
In Gram Staining the differentiation, based on color, divides bacteria into two categories: ___1___ or ___2___.
- Gram-positive
- Gram-negative
______bacteria have a thick cell wall with many overlapping strands of peptidoglycan.
Gram-positive
Gram-positive bacteria have a ___1___ cell wall with many overlapping strands of ___2___.
- thick
- peptidoglycan
A thick peptidoglycan layer provides a ______ to the surrounding environment.
vital protective barrier
True or False: The thick peptidoglycan layer is impermeable, preventing any molecules from passing through to the intracellular space.
False. The thick peptidoglycan layer is not impermeable, meaning select molecules (water, nutrients, etc.) can still pass through to the intracellular space.
The Gram stain exploits this characteristic of the thick peptidoglycan layer by using the dye combinations of ___1___ and ___2___.
- Crystal Violet
- Iodine
Crystal violet is ______ by the thick peptidoglycan cell wall and forms a stable complex with ___2___ (upon its addition) effectively trapping the dyes in the cell. The resulting mixture is a ___3___ coloration of the cell. Thus, Gram-positive cells appear ___3___.
- retained
- iodine
- purple
___1___ bacteria have a relatively thin peptidoglycan layer followed by an outer membrane composed of lipopolysaccharides (LPS).
Gram-negative
Gram-negative bacteria have a relatively ___1___ layer followed by an outer membrane composed of ___2___.
- thin peptidoglycan
- lipopolysaccharides (LPS)
During the Gram staining procedure, Gram-negative bacteria will initially retain the crystal violet dye, however, by next washing the cells with alcohol, a step referred to as the ___1___, the LPS and thin peptidoglycan layers of Gram-negative bacteria are unable to retain the dye, and the outer membrane is depleted of its color.
decolorization wash
True or False: Gram-positive bacteria remain unaffected by the decolorization step.
True
True or False: Gram-negative bacteria remain unaffected by the decolorization step.
False. By washing the cells with alcohol, a step referred to as the decolorization wash, the LPS and thin peptidoglycan layers of Gram-negative bacteria are unable to retain the dye, and the outer membrane is depleted of its color.
To visualize unstained gram-negative bacteria after it has undergone the decolorization wash, a secondary (counterstain) dye called ______ is added.
safranin
By counterstaining with the ___1___ Safranin dye, Gram-negative bacteria now retain a ___2___ color.
- positively charged
- pink
Identify each type of gram staining in the following pictures.
(A) Gram-positive bacillus
(B) Gram-negative bacillus
(C) a mixed culture of Gram-positive coccus and Gram-negative bacillus are shown.
Gram stain distinguishes between bacteria with a thick peptidoglycan wall and those without (or very thin), this is referred to as a ______.
differential stain
______ is a generalized term used for any staining technique that separates specimens into further subgroups. This process most often utilizes at least two dyes.
Differential staining
One of the disadvantages of the Gram stain is the requirement of the cells to be ______ to a glass slide.
fixed (attached)
The most common method to fix a sample is via ______.
heat fixation
In the ______ process, samples are added to a glass slide and then passed through a flame until all liquid in the sample has been removed.
Heat Fixation
What is the Heat Fixation process?
A process for cells to be fixed (attached) to a glass slide for the Gram Staining Process. The samples are added to a glass slide and then passed through a flame until all liquid in the sample has been removed.



